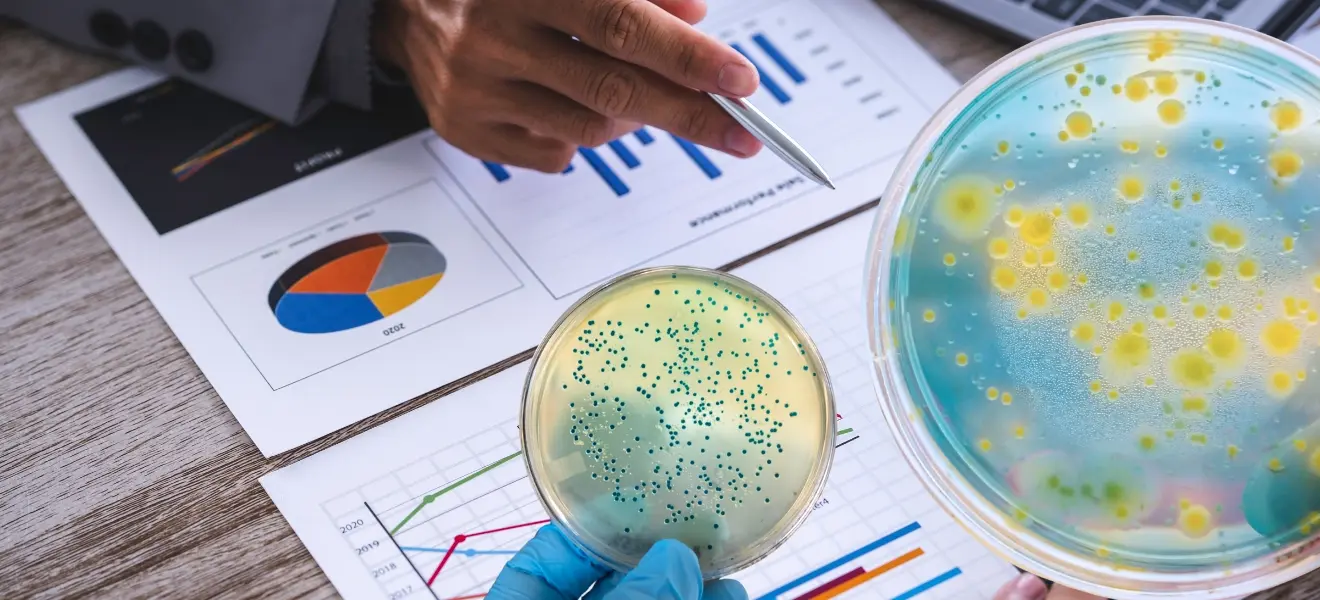
Thumb1

Near Real-Time CCS Monitoring by Walid El Azab | QP Pro Services
Title:
Advanced Data Analysis as an enabler to near real-time
Contamination Control Strategy Evaluation
PDF:
Receive the PDF
Near Real-Time Contamination Control Strategy (CCS)
In sterile manufacturing, contamination control is not a document, it is a living system. This article explains how a near real-time CCS approach connects shopfloor signals, aseptic behaviors, EM trends, and quality decisions to keep your process under control before deviations happen, not after.
Overview
- Translate Annex 1 expectations into a practical CCS structure and governance.
- Build leading indicators (EM, utilities, interventions, glove strategy, cleaning, trends) to anticipate risk.
- Define clear decision rules and escalation pathways for timely QA/QP action.
- Strengthen data integrity and traceability to support inspection-ready evidence.
A near real-time CCS improves consistency, speeds up investigations, and supports smarter batch disposition. It also reinforces a culture where quality signals are acted on early, enabling teams to protect patient safety while sustaining reliable supply.







